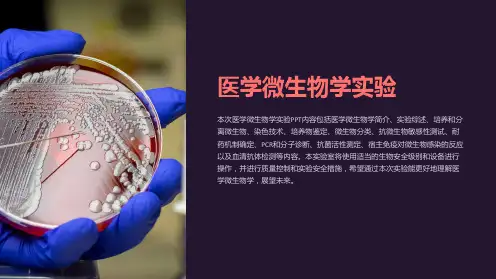

病毒学-微生物学-医学微生物学实验一(6次版)
- 格式:pdf
- 大小:4.13 MB
- 文档页数:29

医学微生物学课程实习实验报告一、实验目的通过本次实验,掌握医学微生物学的基本实验技能,了解细菌、病毒的形态结构及其生理特性,提高观察、分析问题和解决问题的能力。
二、实验原理医学微生物学是研究微生物在医学领域中的分布、分类、形态、生理、致病和免疫等方面的科学。
实验中,通过观察细菌、病毒的形态结构,研究其生理特性,从而为临床诊断和治疗提供理论依据。
三、实验材料与仪器1. 实验材料:细菌、病毒样本,染色剂,培养基等。
2. 实验仪器:显微镜,培养箱,接种环,镊子,无菌棉拭子等。
四、实验步骤1. 细菌观察:(1)制备细菌涂片;(2)革兰染色;(3)显微镜观察,记录细菌形态、大小、排列等特征。
2. 病毒观察:(1)制备病毒样本涂片;(2)荧光染色;(3)显微镜观察,记录病毒形态、大小等特征。
3. 细菌生理特性研究:(1)接种细菌于不同培养基;(2)置于培养箱中培养;(3)观察细菌生长情况,记录菌落大小、形状、颜色等特征。
4. 病毒复制与感染实验:(1)接种病毒于细胞培养液;(2)观察细胞病变情况;(3)记录病毒复制、感染过程。
五、实验结果与分析1. 细菌观察结果:通过显微镜观察,发现细菌分为革兰阳性菌和革兰阴性菌。
革兰阳性菌呈紫色,菌体较大,排列紧密;革兰阴性菌呈红色,菌体较小,排列疏松。
2. 病毒观察结果:通过荧光染色,发现病毒呈圆形或椭圆形,大小约为100-300纳米。
病毒粒子结构清晰,荧光染色剂使其发出绿色荧光。
3. 细菌生理特性研究结果:细菌在不同培养基上的生长情况各异。
例如,大肠杆菌在牛肉膏蛋白胨培养基上生长良好,形成较大菌落,颜色为红色;金黄色葡萄球菌在血平板上生长良好,形成较小菌落,颜色为金黄色。
4. 病毒复制与感染实验结果:病毒接种于细胞培养液后,细胞出现病变现象,如细胞体积增大、细胞膜破裂等。
通过观察病毒复制、感染过程,可以了解病毒的生物学特性。
六、实验结论通过本次实验,掌握了医学微生物学的基本实验技能,对细菌、病毒的形态结构及其生理特性有了更深入的了解。


医学微生物学(卫生部规划教材第6版)电子教案第一章绪论第一节微生物及病原微生物微生物:存在于自然界中,个体微小,结构简单,肉眼直接看不见,必须借助光学显微镜或电子显微镜放大数百倍、数千倍,甚至数万倍才能观察到的微小生物。
微生物的种类非细胞型微生物原核细胞型微生物真核细胞型微生物核酸(DNA/RNA)非细胞型微生物如:病毒(virus)蛋白质核质原核细胞型微生物细胞膜细胞壁如:细菌(Bacterium)衣原体(Chlamydia)支原体(Mycoplasma)立克次体(Rickettsia)螺旋体(Spirochete)放线菌(Actinomycete)细胞核真核细胞型微生物细胞质如:真菌(fungus)细胞膜细胞器微生物及人类的关系益参及自然界中C、N、S等元素的循环。
农业方面:杀虫、造肥、固氮……工业方面:食品发酵、石油脱蜡……医药方面:制药、正常菌群……害引起人类及动植物病害导致工业产品、农副产品和生活用品的腐烂和霉烂。
第二节医学微生物学一、微生物学(microbiology)是研究微生物的类型、分布、形态、结构、代谢、生长繁殖、遗传、进化,以及及人类、动植物等相互关系的科学。
二、医学微生物学发展史1.实验微生物学时期------微生物的发现及病原微生物学的建立Leeuwenhoek----显微镜Pasteur----巴氏消毒法Koch----分离细菌,郭霍法则Iwanovsky----烟草花叶病毒Loeffler,Frosch----口蹄疫病毒Walter-Reed----黄热病毒Twort----噬菌体2.实验微生物学时期---抗感染免疫、化学疗法及抗生素的发现Jenner----牛痘预防天花Pasteur----霍乱、炭疽、狂犬疫苗Behring----白喉抗毒素меЧНИкоВИИ----吞噬细胞学说Ehrlich----体液抗体学说Wright----体液免疫、细胞免疫Ehrlich----砷凡纳明Fleming,Florey----青霉素3.现代微生物学时期(1)新病原微生物的发现 :朊病毒,军团菌,幽门螺杆菌,人类免疫缺陷病毒,疯牛病,埃博拉病毒,冠状病毒,禽流感H5N1(2)病原微生物致病性的认识内源性感染,细菌耐药性,分子水平上的致病机制的研究……(3)微生物学诊断技术快速、准确、简易 ELISA,PCR……(4)微生物的防治措施新型疫苗的研制 : 核酸疫苗,基因工程疫苗……(周亚滨)第一篇微生物学的基本原理第二章微生物的生物学性状第一节细菌一、细菌的大小及形态1.细菌的大小 ------观察仪器:光学显微镜测量单位:微米(μm)球菌(coccus)2.细菌的形态----- 杆菌(bacillus)螺形菌(spiral bacterium)二、细菌的基本结构(一)、细胞壁(cell wall)------位于细菌细胞的最外层,包绕在细胞膜的周围,组成较复杂,并随不同细菌而异。

呼吸道病毒
附注:
(1)正黏病毒包膜上的两种刺突
(2)麻疹病毒的致病机制:
麻疹病毒经呼吸道进入机体f感染麻疹病毒受体CD46分子的靶细胞,在其中增殖一侵入淋巴结增殖一入血(第一次病毒血症)f同时病毒在全身淋巴组织中大量增殖后再次入血(第二次病毒血症)f出现上呼吸道卡他症状(发热、病毒感染结膜、鼻咽黏膜和呼吸道黏膜引起)
f病愈后一周,0.1%的患者可以发生迟发型过敏反应疾病,引起脑脊髓炎,伴有永久后遗症,病死率为15%。
f恢复后数年或学龄前,百万分之一的患者可以发生亚急性硬化性全脑炎(SSPE),为急性病毒感染的迟发并发症,表现为渐进性大脑衰退,一般在1-2年内死亡。
(3)冠状病毒:
1、非分节段的单正链RNA
2、普通感冒和咽喉炎、严重急性呼吸道综合征
3、无疫苗
4、基因组最大的RNA病毒
肠道病毒
无包膜的小RNA 病毒,衣壳为二十面体立体对称,基因组为单正链RNA 。
能在有相应病毒识别受体的易感细胞中增殖,迅速产生病变 对理化因素抵抗力较强,对酸具有一定的抵抗力,能耐受蛋白酶和胆汁的作用,对乙醚、 去垢剂有一定抗性。
免疫力持续时间短
共同特征: 1、
2、
3、
急性胃肠炎病毒
虫媒病毒
指通过吸血的节肢动物叮咬易感的脊椎动物而传播疾病的病毒。
①病毒能在节肢动物体内增殖,并可经卵传代。
因此节肢动物既是病毒的传播媒介,又是储存宿主。
②大多数是自然疫源性疾病,也是人畜共患病。
③明显的地方性和季节性。
其余病毒。

医学微生物学实验报告(本科)实验室:姓名:学号:班级:海南医学院微生物学与免疫学教研室编写二OO四年四月第一次实验【实验内容】实验一微生物的形态与结构的观察实验二微生物的分布【结果记录及判定】实验一微生物的形态与结构的观察1、细菌正常形态及特殊结构的观察及记录(示教):绘图并描述形状:形状:排列:排列:染色性:特殊结构:霍乱弧菌破伤风梭菌芽胞形状:形状:排列:排列:特殊结构:特殊结构:肺炎链球菌荚膜伤寒沙门菌鞭毛形状:形状:排列:排列:特殊结构:特殊结构:炭疽杆菌脑膜炎球菌2、病毒包涵体观察及记录(示教):绘图并描述描述:狂犬病毒包涵体(H-E染色)3、真菌的形态观察及记录(示教):绘图并描述形状:形状:排列:排列:特殊结构:特殊结构:白假丝酵母菌皮肤癣菌4、革兰染色法结果观察及记录:绘图并描述形状:形状:排列:排列:染色性:染色性:葡萄球菌大肠埃希菌实验二微生物的分布结果记录:1、空气中的细菌种类(种):数量(个):2、水中细菌数检测(1)自来水中细菌的种类(种):数量(个):(2)污水中细菌的种类(种):数量(个):3、物品和手指上的细菌检查(记录本人结果)物品表面的细菌种类(种):数量(个):手指表面的细菌种类(种):数量(个):结论:成绩:_________________批改教师签名:____________批改时间:________________第二次实验【实验内容】实验三微生物的分离培养实验四抗菌药物敏感性试验实验五消毒、灭菌、除菌【结果记录及判定】实验三微生物的培养1、细菌分离培养方法(分区划线接种法),生长现象为:2、纯种细菌接种技术(1)琼脂斜面接种培养,大肠埃希菌生长现象:(2)液体培养基接种法,大肠埃希菌生长现象:(3)半固体培养基接种技术①标本名称:大肠埃希菌半固体培养基②标本名称:痢疾志贺菌半固体培养基穿刺线:穿刺线:培养基:培养基:结论:结论:3、沙保弱琼脂平板上的真菌菌落观察及描述(示教):类酵母型菌落:丝状菌落:实验四抗菌药物敏感性试验实验五消毒、灭菌、除菌一、紫外线灭菌法(示教)玻璃盖遮住平板的一半现象:现象:分析:分析:二、机械除菌法(示教):1、未经过滤的液体培养基培养后的现象:2、经过过滤的液体培养基培养后的现象:分析:成绩:_________________批改教师签名:____________第三次实验【实验内容】实验六细菌的致病性实验七化脓性感染的细菌学检查【结果记录及分析】实验六细菌的致病性一、透明质酸酶试验(示教,实验动物:家兔)测量试验侧与对照测的黑墨水扩散范围(cm×cm):实验侧:对照侧:分析:二、破伤风外毒素的毒素作用(实验动物:小鼠)实验现象:实验侧:对照侧:分析:实验七化脓性感染的细菌学检查一、病原性球菌的形态观察(示教):绘图并描述形状:形状:排列:排列:染色性:染色性:葡萄球菌链球菌形状:形状:排列:排列:染色性:染色性:脑膜炎奈瑟菌淋病奈瑟菌二、病原性球菌的鉴别:三、血清学试验抗“O”试验(乳胶凝集法)实验现象:阳性对照:阴性对照:标本1:标本2:结果判定:标本1为________,标本2为_________。

医学微生物学实验课件xx年xx月xx日contents •实验准备•细菌的分离与培养•细菌的鉴定•病毒的分离与鉴定•医学寄生虫实验•医学微生物学实验总结目录01实验准备1 2 3通过本次实验,学生将学习到微生物学实验的基本技能,包括实验操作、显微观察、分离培养等。
掌握微生物学实验基本技能通过实验过程中的生理生化反应,学生将了解微生物的生理生化特性,初步掌握微生物分类鉴定的基本方法。
了解微生物的生理生化特性通过本次实验,学生将了解微生物在医学中的应用,包括致病微生物的检测、防治和免疫等方面的应用。
认识微生物在医学中的应用微生物学实验基本原理微生物学实验的基本原理包括显微镜技术、无菌技术、分离培养技术、生理生化反应等。
这些技术的基本原理是进行微生物学实验的基础。
微生物的生理生化反应微生物的生理生化反应是微生物学实验中的重要内容。
通过观察和测定微生物的生理生化反应,可以初步鉴定微生物的种类和特性。
微生物在医学中的应用微生物在医学中有着广泛的应用,例如致病微生物的检测、防治和免疫等。
通过本次实验,学生将了解这些应用的基本原理和方法。
实验前的准备包括实验器材和试剂的准备、实验室环境的消毒等。
分离培养将样品接种在适宜的培养基上,分离培养出特定的微生物。
样品采集和预处理根据实验目的和要求采集样品,并对样品进行预处理,以备后续实验使用。
生理生化反应将分离培养出的微生物接种在适宜的生理生化反应管中,观察和记录微生物的生理生化反应结果。
显微观察将样品制成涂片或压片,在显微镜下观察微生物的形态和结构。
数据分析和总结对实验数据进行整理和分析,得出结论,并撰写实验报告。
实验步骤02细菌的分离与培养选择适合细菌生长的培养基,通常包含碳源、氮源、无机盐、水等。
培养基成分按照规定的步骤,将所需成分按比例混合、溶化、调PH值、过滤、分装等步骤制备成培养基。
制备流程确保培养基的质量和无菌,需要进行灭菌处理和细菌学检测。
质量控制培养基制备根据不同的分离要求,可采用划线分离法、稀释分离法、组织研磨法等。

医学微生物学实验报告实验目的本实验旨在通过对微生物的观察和鉴定,了解微生物的形态特征和生理特性,培养学习医学微生物学基本实验技术。
实验材料与方法1. 实验材料•活菌培养基•微生物培养物(包括葡萄球菌、大肠杆菌等)•显微镜和玻片•消毒液和消毒棉球•培养皿和接种环2. 实验方法步骤一:准备工作1.每个实验者佩戴好实验室服装,戴上口罩和手套,保证实验操作的无菌环境。
2.准备洁净的实验台面和所需实验器具。
步骤二:微生物培养1.取一块洁净的玻璃钢笔杆,在一盖玻片上滴一滴细菌液体培养物。
2.将滴有细菌液体的玻片倒置在洁净的培养皿内,并将盖玻片放在培养皿内,避免细菌液体外溢。
3.用接种环将细菌液体均匀地涂抹在活菌培养基上。
4.将培养皿盖好,放入恒温培养箱中,在适当的温度下培养。
步骤三:观察和鉴定1.取出培养好的菌落,放在显微镜的载玻片上。
2.用显微镜先进行低倍观察,调整镜头至清晰度适中,观察菌落的整体形态和颜色特征。
3.然后切换到高倍观察,观察菌落的细胞形态、大小和排列方式。
4.若有需要,还可以进行染色等特定试验,以进一步鉴定菌落的类型。
步骤四:记录和总结1.将观察到的菌落形态特征和鉴定结果记录在实验笔记上,包括颜色、形状、大小和排列等。
2.根据观察和鉴定的结果,总结各种微生物的形态特征和生理特性。
3.进行实验结果的讨论和思考,与其他实验者交流经验和观点。
实验结果与讨论经过实验观察和鉴定,我们成功培养并观察到了不同种类的微生物菌落。
通过低倍和高倍显微镜观察,我们发现不同菌落之间存在明显的形态差异。
有些菌落呈现出圆形,有些呈现出不规则的形状。
菌落颜色也有所不同,有的呈现出乳白色,有的呈现出黄色或粉红色。
在菌落的细胞形态观察中,我们发现一些细菌呈现出链状排列,而另一些呈现出聚集在一起的形态。
细菌的大小也存在差异,有些较为粗大,有些较为纤细。
根据我们的观察和鉴定结果,我们可以初步确定观察到的菌落为不同种类的细菌。
这些微生物的形态特征和生理特性可能与它们的菌属和菌种有关。